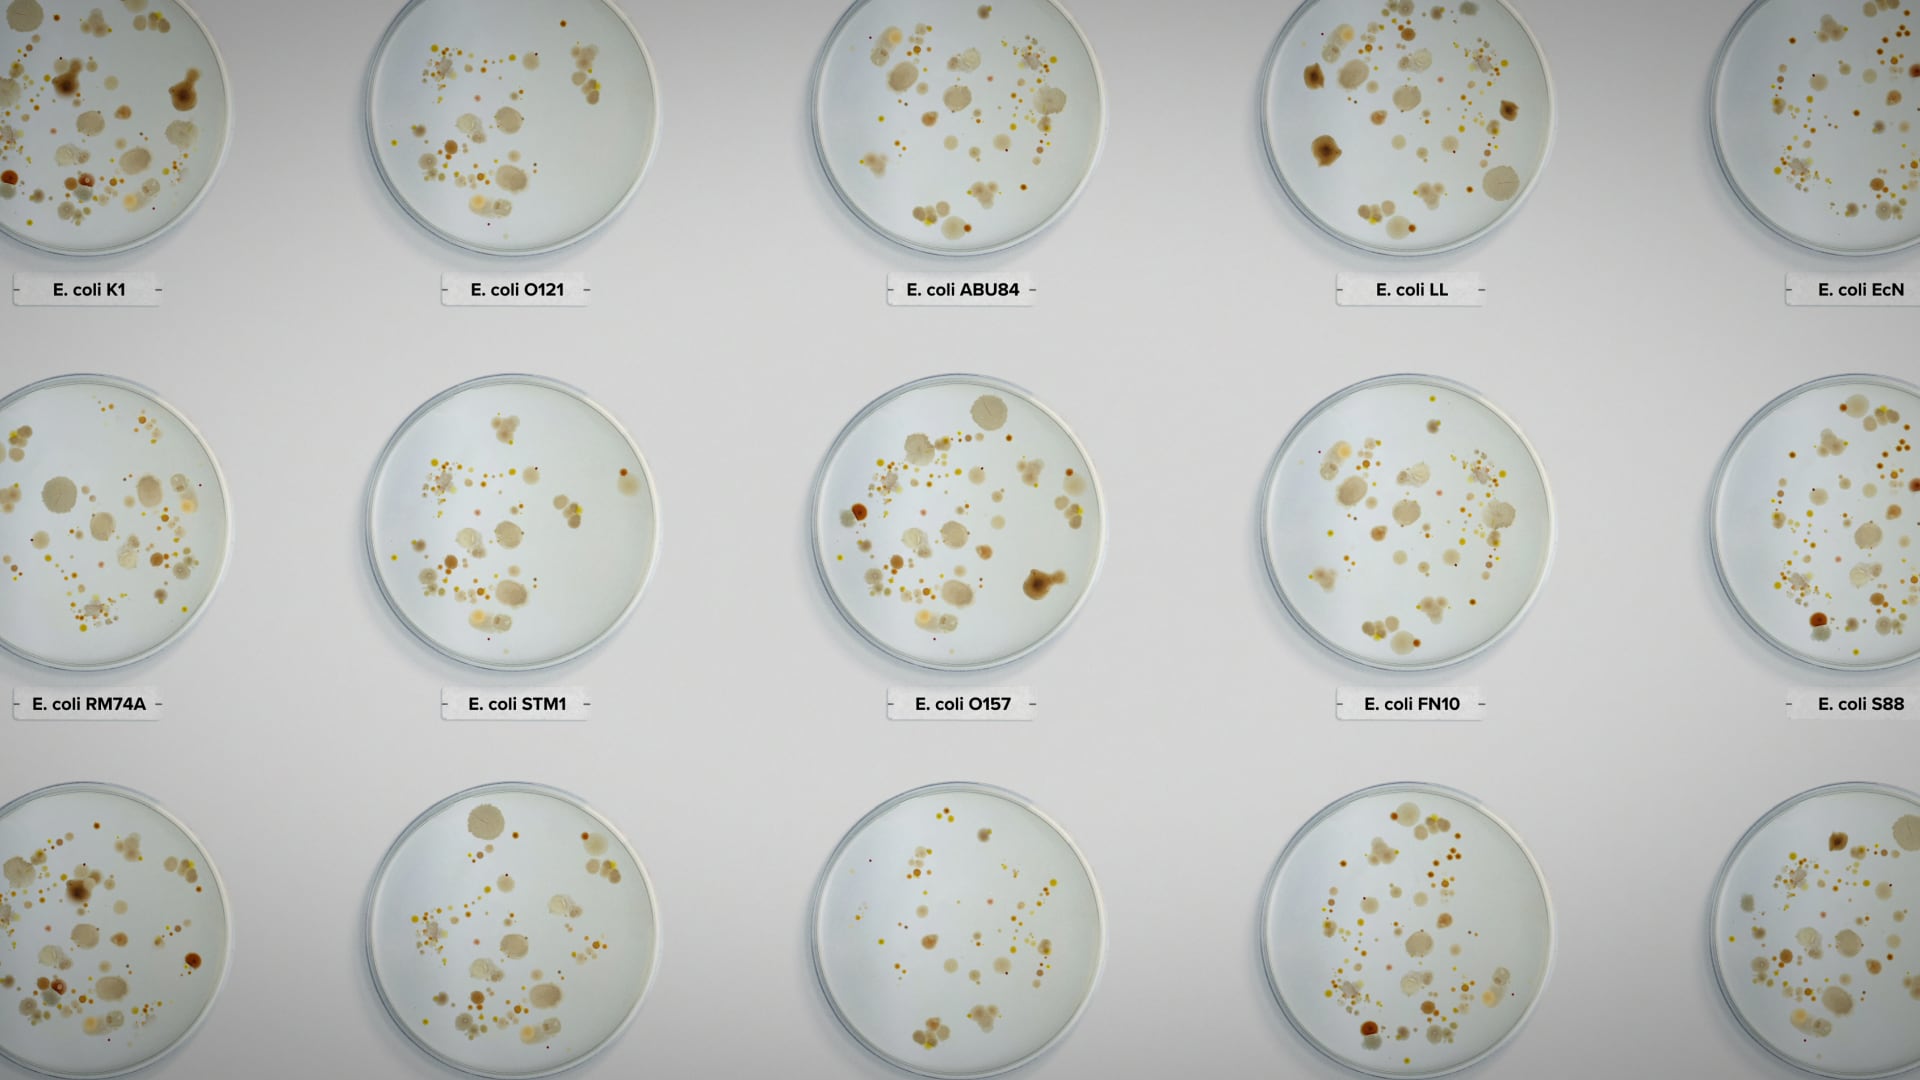

Netflix estrenó hace unos días el documental Intoxicación: la cruda verdad de nuestra comida (Poisoned: The Dirty Truth About Your Food) y ofrece un nuevo enfoque dentro del género documental de su catálogo que aborda habitualmente historias de crímenes. Adaptado del revelador libro de 2011 de Jeff Benedict, Poisoned, este título destaca las negligencias en la seguridad alimentaria, centrando su atención en el brote mortal de E. Coli que cambió las percepciones sobre la alimentación de Estados Unidos.
La obra de Benedict pone de manifiesto la grave situación que afecta a la industria de alimentos y a sus reguladores. Tanto la investigación original de 2013 como el documental recién lanzado por el gigante de la “N” hacen un llamado a la responsabilidad, y señalan cómo la desidia de las autoridades ha dejado a los consumidores a merced de patógenos letales.

Esta producción revela fallos en la industria de los alimentos en EE. UU. (Netflix)
“En este país, si compras aves de corral en cualquier supermercado, sin importar la marca, deberías asumir que contiene patógenos como salmonela y campylobacter”, menciona uno de los especialistas consultados durante la filmación. Stephanie Soechtig, conocida por su enfoque incisivo en documentales anteriores que abordan temas polémicos, dirige esta obra. Su experiencia en la industria alimentaria con títulos como Tapped y GMO OMG le ha otorgado la perspicacia necesaria para dirigir Intoxicación.
Jeff Benedict, además de ser el autor del libro, actúa como productor ejecutivo junto con Rebecca Evans y Ross Girard. Ross M. Dinerstein y Kristin Lazure aportan su experiencia como productores y respaldan el proyecto. Rod Hassler, como cinematógrafo, y Justin Melland, como compositor, garantizan que cada elemento del film esté meticulosamente pulido.

«Intoxicación: la cruda verdad de nuestra comida» pone a la seguridad alimentaria en tela de juicio. (Netflix)
Uno de los puntos culminantes es la aparición de Bill Marler, el abogado que ha pasado 30 años defendiendo la seguridad alimentaria. Su dedicación y experiencia en la lucha contra la negligencia en la industria proporcionan un valioso punto de vista humano al escenario técnico y regulatorio. Intoxicación: la cruda verdad de nuestra comidaobtuvo reconocimiento tras ser seleccionado para el Festival de Cine de Tribeca, una ventana clave para producciones cinematográficas influyentes.T
El documental promete no sólo educar a los espectadores sobre los riesgos ocultos en su comida, sino también inspirar a una nueva generación a exigir un cambio en las prácticas y regulaciones de la circulación de alimentos. Con la creciente preocupación global sobre la seguridad y la transparencia en la producción de estos mismos, podría ser el catalizador para un cambio significativo en cómo los consumidores ven y consumen la comida.
El brote de E. Coli bajo la lupa, ¿está comprometida nuestra alimentación? (Netflix)
Intoxicación: la cruda verdad de nuestra comida tiene una hora y 22 minutos de duración. Se puede ver en Netflix.
Fuente: Infobae